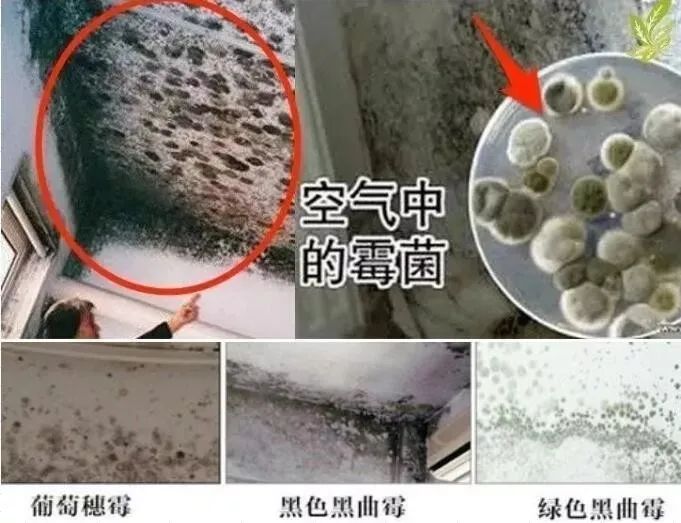

可怕的梅雨季刚过,是不是发现不止家里一股闷馊味,墙壁上迅速扩张的霉斑,简直恶心到头皮发麻!

可别小瞧这些霉菌,它们有着类似蘑菇的“喷洒孢子”的传播方式。
在你看不见的角落里,霉菌每天都静静的把孢子发射到空气中,不间断的高效传播,释放霉菌毒素!

被吸入人体后,会引发过敏、皮肤感染和呼吸道问题。
据统计,这个隐形的杀手毒性大起来能赶超砒霜,每年因霉菌致癌的人就有30000人!


这些毒素中,黄曲霉素,就被世界卫生组织列为一类致癌物,有明确致癌作用。

除霉防霉,一定要引起重视!
经过多组对比测试,小编终于找到了一款轻松除霉,一喷即净,安全无毒的除霉剂——芳贝斯除霉剂。


除霉+防霉+护理,三效合一!自己在家动动手,就能拥有洁白干净的墙面。

快速除霉 芳贝斯墙体除霉剂500ml
除霉+防霉+护理 三效合一
粉丝特惠:39元/瓶 日常价89元
买2瓶立减10元
在使用这款芳贝斯墙体除霉剂之前,以前家里墙壁起霉了,这是束手无策。
用抹布强行把霉菌抹去,墙皮都蹭掉了,还是一片乌漆墨黑。
找工人师傅上门粉刷遮盖,霉菌“春风吹又生”,浓浓的甲醛要通风多久才能散去?

不需要繁复的操作,有了芳贝斯墙体除霉剂,就能自己在家翻新墙面。
为了防止霉菌沾染皮肤,使用前大家最好戴上手套和口罩,开窗通风。
摇一摇瓶身后,将喷头旋转至“ON”,再用喷雾对着霉斑处均匀喷洒。

静置1~5分钟,就能看见霉斑渐渐消失,对比效果惊人啊。

不像市面上普通的除霉剂,芳贝斯后续无需用水冲洗。
达到自己满意净白后,用干布吸干墙面水汽即可。
双手完全不用接触一滴水和霉菌,就能重获一面大白墙。

一般来说,早期的霉斑,2分钟左右就能起效。顽固斑渍可以再进行重点补喷。
这面开满了花的墙,才3分钟就被翻新了。

还有一个“野生”买家秀,直接在户外的墙壁大秀除霉。
真的像魔术一样,连开裂的墙缝里,都被喷干净了~

看见就皱眉的黑墙角,眼看着就要长蘑菇了。用了除霉喷雾,就像被粉刷一新一样。

不光是白墙可以用,家里贴了壁纸的墙面,也可以放心使用,不会影响花色。

被梅雨季光顾的木质衣柜,一定要记得清理,避免污染衣物、被褥,这可是直接接触身体的!
不妨用这款除霉喷雾试试,一喷除霉,守护家人健康。

快速除霉 芳贝斯墙体除霉剂500ml
除霉+防霉+护理 三效合一
粉丝特惠:39元/瓶 日常价89元
买2瓶立减10元
霉菌是一种浓度低毒性高,而且能积累耐高温的毒素,生命力非常顽强。
当我们长期反复暴露在霉菌环境中,对健康的危害可不小!致敏、致畸、致癌的风险也一度攀升。

但是现在市面上很多打着“立竿见影”旗号的产品,都含有大量化工添加剂!
特别是有老人、小孩、孕妇的家庭,在选择除霉产品时,一定要选择更安全环保的。

而这款除霉喷雾的主要成分是生物酶,是一种由活细胞产生的有机物催化剂。
它的催化效率是一般无机催化剂的1000万倍以上!

整个除霉过程,就是一个安全的生物降解过程:
孢子和霉菌最终会被分解成无毒无害的二氧化碳和水。

安全快速有效地去除顽固霉菌,一瓶芳贝斯就够了。
快速除霉 芳贝斯墙体除霉剂500ml
除霉+防霉+护理 三效合一
粉丝特惠:39元/瓶 日常价89元
买2瓶立减10元
原来置之不理的一个小霉斑,凭着惊人的“长速”,一天都能在墙上连成一幅水墨画。
感觉自己和一堆螨虫细菌霉菌住在一起,真的是太难受了!!!

黑科技的生物技术,使喷洒液体由外向内深度渗入墙体分解菌体,达到深层除霉祛菌的效果。
一次性祛除看得见、看不见的霉斑、霉菌。

分解后的生物酶,还会在墙体表面形成一层保护膜,以此来抑制霉斑再生,做到根源性地清除霉菌。
不仅防止霉斑的复发,还能抑制细菌的滋生。

这款除霉剂经过多年的实验调试,经过上千次的专业测试,不易损伤墙面,不易掉屑掉皮,还能起到养护墙面的作用。

阳台的天花板总是容易反反复复滋生霉斑,有了它的帮忙,多年的心病总算是化解了。

没有了闷闷的霉味,每一次打开窗户都能送进清新的风,生活质量和幸福指数蹭蹭往上~

厨房卫浴的卫生死角和瓷砖缝,清洁起来总是很头疼。

霉菌和水垢混为一谈,就算拿着细小的牙刷也总是清理不干净。

像这种清洁死角,小编特别推荐用这款除霉剂试试,细密的喷雾能瞬间深入降解霉菌,达到快速除霉的效果。

水池边霉斑,用它清洁起来比钢丝球还给力多了。

使用过这款除霉剂的朋友都觉得相见恨晚,原来困扰多年的霉菌问题,有它就能轻松解决了。

多雨的春季,除霉、防霉正当时,建议根据居家面积一次多瓶购买~
日常售价89元/瓶的芳贝斯,限时特惠39元/瓶
买2瓶立减10元!仅限前1000名顾客享有哦~

除霉+防霉+护理 三效合一
粉丝特惠:39元/瓶 日常价89元
买2瓶立减10元


已同步到看一看
写下你的想法